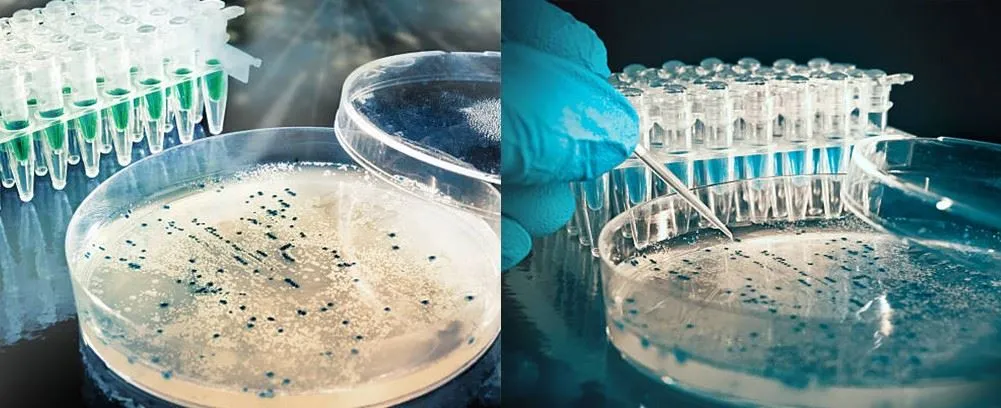

Mias Petri Plaisteacha 100mm
Is mír saotharlainne indiúscartha é mias petri plaisteacha, arb é atá ann bun agus clúdach. De ghnáth, tá miasa petri plaisteacha steiriliú EO nó steiriliú GAMMA.
Cur síos
Mias Petri plaisteach 100mm
Is mír saotharlainne indiúscartha é mias petri plaisteacha, arb é atá ann bun agus clúdach. De ghnáth, tá miasa petri plaisteacha steiriliú EO nó steiriliú GAMMA.
Tá méideanna coitianta 35mm, 60mm, 90mm, 100mm agus 150mm. Tá ár miasa petri plaisteacha ar fad ar ardchaighdeán agus trédhearcacht ard. Táimid ag díriú ar fhorbairt táirgeachta agus ar rialú cáilíochta, rud a fhágann go bhfuil dea-cháil againn ar fud an domhain.
|
Ainm Táirge |
mhias Petri plaisteach 100mm |
|
Méid |
100m*15mm |
|
steiriúil |
EO nó GAMMA |
|
OEM |
Cuireadh fáilte roimh |
|
Pacáil |
10pcs / mála, 500 ríomhaire / ctn |
|
Ábhar |
plaisteach |
|
sampla |
Ar fáil |
● Buntáiste
Cuirtear claibíní ar fáil do gach méid; cruachta éasca; soiléir.
Iarratas
Úsáidtear é go ginearálta i micribhitheolaithe agus bhí meán cultúir ann inar féidir baictéir a fhás agus a staidéar. Úsáidtear go forleathan é i saotharlanna ceimiceacha agus scoil mar gheall ar a shábháilteacht.

QRialú uality

Pacáil,Stóráilagus Iompar
● Pacáiste
10pcs/ctn, 500pcs/ctn. Pacáil i gcartán saoi atá ag leanúint leis an gcaighdeán. Scríobhfar gach sonraíocht thábhachtach táirge ar an gcás seachtrach.
● Stóráil
I bhfad ar shiúl ó ábhar fliuch agus nimh. Ní mór é a stóráil sa seomra.
● Iompar
Tá cuideachtaí FedEx, DHL, UPS, EMS, Loingseoireachta ar fáil. Le haghaidh sampla, ba mhaith linn a sheoladh trí chúiréireachta, le haghaidh ordú mórchóir, ba mhaith linn a sheoladh ar long nó aer.

FAQ
1. An féidir miasa petri plaisteacha a bheith agam i GAMMA steiriúil?
Tá. Ach tá na praghsanna difriúil ó EO steiriúil.
2. Cad é do théarma íocaíochta samplach?
Maidir le samplaí, T/T 100 faoin gcéad roimh ré.
3. An féidir sampla a bheith agam?
Ar ndóigh, is féidir leat.
Clibeanna Te: mhias petri plaisteach 100mm, an tSín, soláthróirí, monaróirí, monarcha, saincheaptha, mórdhíola, praghas, pricelist, sampla saor in aisce













